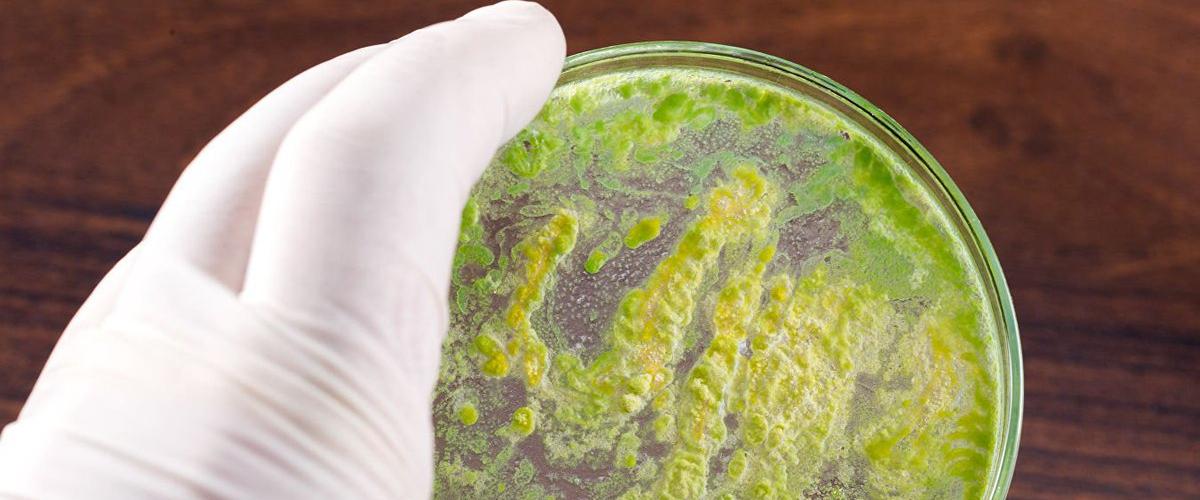
TODO:

В ответ на внешнее воздействие, например, освещение синим светом, бактерий Bacillus subtilis меняют потенциал клеточной мембраны. Похожий, но более сложный механизм, лежит в основе работы человеческих нейронов. Это значит, что, изучая свойства бактерий, можно лучше понять ранние этапы эволюции нервной системы.
Исследователи из Калифорнийского университета в Сан-Диего обнаружили у бактерий еще одно необычное свойство, сближающее их с нейронами, — способность к сохранению «воспоминаний». Как сообщает Phys.org, ученые провели эксперимент, в ходе которого воздействовали синим светом на определенные участки биопленки Bacillus subtilis, отпечатав на ней логотип своего университета. Рисунок, образованный флуоресцентным веществом тиофлавином, сохранялся на поверхности биопленки на протяжении нескольких часов после отключения источника света и в условиях колебаний потенциала, вызванных дефицитом глутамата.
Иными словами, отдельные бактерии сохранили информацию о предыдущем состоянии окружающей среды. По мнению авторов, это говорит о наличии своеобразной формы памяти.
Открытие не только позволяет больше узнать о природе памяти, но и дает надежду на создание сложных вычислительных систем на основе бактерий. Отдельные цепи таких систем можно было бы закодировать в отдельных областях биопленки.
Некоторые бактерии умеют вырабатывать собственное электричество, однако попытки использовать их в производстве батарей до сих пор не приводили к успеху. Прорыв в этой области удалось совершить немецким ученым, которые создали биогибридную батарею на основе гидрогеля.